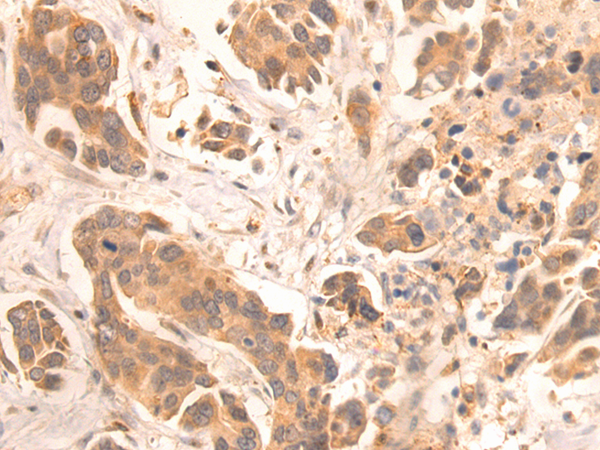
一抗

中文名稱:兔抗ZKSCAN3多克隆抗體
|
Background: |
Transcriptional factor that binds to the consensus sequence 5'-[GT][AG][AGT]GGGG-3' and acts as a repressor of autophagy. Specifically represses expression of genes involved in autophagy and lysosome biogenesis/function such as MAP1LC3B, ULK1 or WIPI2. Associates with chromatin at the ITGB4 and VEGF promoters. Also acts as a transcription activator and promotes cancer cell progression and/or migation in various tumors and myelomas. |
|
Applications: |
ELISA, IHC |
|
Name of antibody: |
ZKSCAN3 |
|
Immunogen: |
Fusion protein of human ZKSCAN3 |
|
Full name: |
zinc finger with KRAB and SCAN domains 3 |
|
Synonyms: |
ZF47; Zfp47; ZFP306; ZNF306; ZNF309; zfp-47; ZSCAN13; ZSCAN35; dJ874C20.1; dJ874C20.1. |
|
SwissProt: |
Q9BRR0 |
|
ELISA Recommended dilution: |
5000-10000 |
|
IHC positive control: |
Human gastric cancer |
|
IHC Recommend dilution: |
25-100 |

 購物車
購物車 幫助
幫助
 021-54845833/15800441009
021-54845833/15800441009